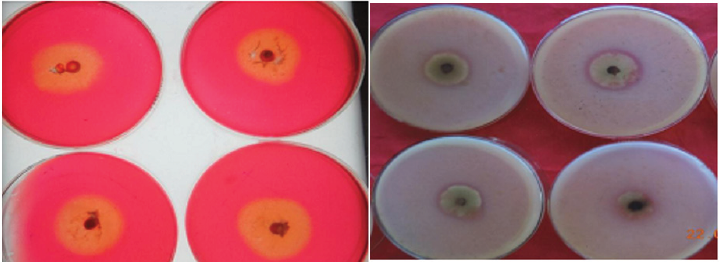
Click here to view Large image 2

David Kamei1 and Archana U Singh2*
1KVK, ICAR, India
2Division of Nematology, ICAR-IARI, India
*Corresponding author: Archana U Singh, Division of Nematology, ICAR-IARI, India
Submission: October 25, 2021;Published: December 06, 2021
Volume3 Issue3December, 2021
Rice is an important Cereal and staple food for human population. In the present study a major fungal pathogen (Helminthosporium oryzae) causing brown spot disease of Rice was studied. Isolation, Characterization and Extra-cellular enzymatic activities of the pathogen Helminthosporium oryzae was carried out for confirming pathogenic nature of fungus causing Brown Spot Disease of Rice.
Plant disease causes major threats to human welfare as they contribute huge economic losses, food insecurity, resulting social unrest and problems globally. Rice is a staple food to more than half of the world’s population and to two third population of India [1]. This single most important cereals crop was inflicted by various diseases of fungus, bacteria, viruses, nematodes and mycoplasma pathogens. Losses due to rice diseases have been estimated to be 10-15% in general [2]. Among these diseases brown spot disease caused by Helminthosporium oryzae (Breda de Haan) a fungal pathogen is one major disease that causes enormous losses in grain yield (upto 90%) particularly when leaf spotting phase assumes epiphytotic proportions as observed in Great Bengal famine in 1942-43 [3]. Keeping in view of the economic losses and ever increase demand of rice as major component of food security thus isolation, characterization and extra-cellular enzymatic activities of the pathogen Helminthosporium oryzae was carried out for confirming pathogenic nature of fungus causing Brown Spot Disease of Rice.
Isolation of disease pathogen Helminthosporium oryzae and maintaining of pure culture
Helminthosporium oryzae was isolated from infected plant parts of rice by following method [4]. The rice leaves showing characteristic symptoms of brown spot were collected from experimental paddy fields of Sam Higginbottom University of Agricultural, Technology and Sciences (SHUATS), Naini, Prayagraj, (U.P.) and brought into the laboratory was cut into small pieces of 1mm slices and surface sterilized in 0.1% mercuric chloride (HgCl₂) for 1 minute and then rinsed with sterile water for 3 times. Three segments of these disease inoculum leaf pieces was inoculated in petri plates containing sterilized PDA medium and incubated at 26±1 ºC. After 48 hours of incubation whitish cottony growth of mycelium appeared in the petri plates. To obtain pure culture, tip of this mycelium was cut with the help of sterilized inoculating needle and transferred into fresh sterilized PDA slants and then incubated at 26±1 ºC in BOD incubator for 144 hour. The isolated pathogen culture was then observed in microscope by preparing slides and pathogen was identified following standard characterization procedures. The pathogen pure culture thus obtained was maintained in PDA slants and stored in refrigerator at 4 ºC and sub cultured from time to time.
Characterizations of Helminthosporium oryzae
Observations recorded under computerize microscopic camera, Helminthosporium oryzae mycelium initially was hyaline or white cottony growth turning brown and blue black as it grows older. Myceliums are filamentous, cylindrical with septation and having constriction at the point of branching Figure-1(a) &1(b). The conidia are globule with bulged at the centre and tapering at both ends. The conidia are pale brown or yellowish in colour having 4-9 Pseudo septation. The conidia length varied from 84.18-96.26μm and width 18.80-26.05μm Figure-1(c). These characteristics were in corroborate with that of Ou SH [5] who described that culture of H. oryzae was grey to olive or black in colour, conidia are 5-10 septa with slightly curved and widest at the middle. Mature conidia are sub-hyaline. Motlagh MRS et al. [4] also reported that conidia of H. oryzae isolates in India has been observed between 99-135 x 7-11μm and 24-122x7.23μm, usually curved, obclavate, sometime almost cylindrical, pale to mid golden brown, 5-12 distoseptate, mycelium grey to dark grey, aerial mycelium was fluffy, cottony, olivaceous with brownish tinge and septate.
Figure 1(a): Brown spot pathogen of (H. oryzae) mycelium on PDA.
(b): Microscopic view of isolated H. oryzae mycelium and conidia.
(c): Microscopic view of conidia H. oryzae.

Extra-cellular enzymatic activities test for confirmation of pathogenic nature of the Helminthosporium oryzae isolates
A. Cellulase activity
For enzymatic activities test of the fungal isolates (Helminthosporium oryzae) method of Asoufi H et al. [6] was adopted. The cellulose activity of H. oryzae isolates was measured by culturing them with Carboxymethyl Cellulose Agar (CMCA) medium (carboxy methyl cellulose-5.0gm, agar-17.0gm, distilled water-1000ml), 5mm mycelial discs from the margin of actively growing 5 days old pure culture were aseptically inoculated and incubated in BOD at 24 ºC. Three replications was maintained for each isolates. After 3 days of incubation, the culture plates were flooded with 1%w/v of Congo-red for 1hr at room temperature and excess stain was discarded and the agar plate was thereafter de-stained with 1M of NaCl solution. Plates were kept overnight at 4 °C and then examined for development of orange clear zone in substrate around the point of inoculation with reference to the control plate. The diameter of the clear zone was measured, recorded and documented. Cellulase activity was expressed as the ratio between clear zones of mycelial growth.
B. Pectinase activity
The method of Hagerman et al. was followed for pectinase activities test of pathogenic fungus. Fungal isolates was grown on Pectin agar media (pectin-5.0gm, yeast extracts-5.0gm, agar- 16.0gm, and distilled water-1000.0ml). Plates with 2 days old growth was stained with 0.05% Ruthenium red solution for 3 hours and then thoroughly washed with distilled water twice. The colour turned dark pink and a transparent zone was formed where pectin was utilised by the fungal isolates. The diameters of both the transparent and fungal growth zones was measured and activity is expressed as the ratio between clear zones of mycelial growth. The above cellulose enzymatic test resulted an appearance of clear orange zone around the fungal (H. oryzae) inoculated spot. Likewise in case of pectinase test the substrate media colour turned dark pink and a transparent zone developed around the fungal isolates (H. oryzae) inoculated spot. The above characteristics obviously indicated that the fungal isolates are highly pathogenic in nature Figure-2(a) & 2(b).
Figure 2(a): Cellulase enzymatic activity on H. oryzae isolates with appearance of orange colour clear zone.
(b): Pectinase enzymatic activity on H. oryzae isolates appearance turning pink colour with clear zone.
In this study isolation, characterization and extra-cellular enzymatic activities of the pathogen Helminthosporium oryzae was carried out for confirming pathogenic nature of fungus causing Brown Spot Disease of Rice.
© 2021 Archana U Singh. This is an open access article distributed under the terms of the Creative Commons Attribution License , which permits unrestricted use, distribution, and build upon your work non-commercially.
a Creative Commons Attribution 4.0 International License. Based on a work at www.crimsonpublishers.com.
Best viewed in